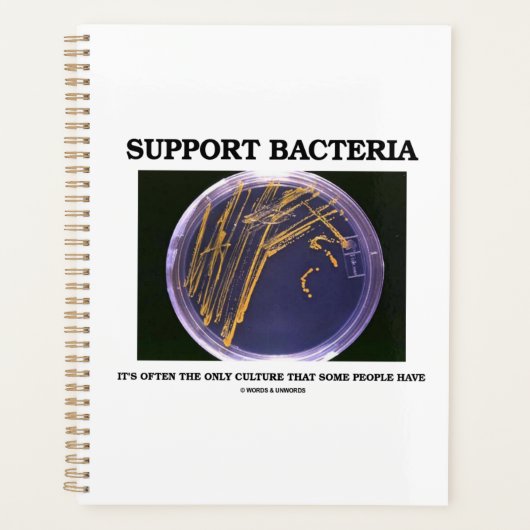
Unterstützung Bakterien oft nur Kultur Einige Leut Planer (Vorderseite)

42,35 €
pro Planner
Unterstützung Bakterien oft nur Kultur Einige Leut Planer
Produkt-Details anzeigenÜber Planner
Verkauft von
Über dieses Design
Unterstützung Bakterien oft nur Kultur Einige Leut Planer
Es ist nicht notwendig, Bakteriologe, Mikrobiologen oder Biologen zu sein, um diesen Wangen-wissenschaftlichen Sprichwort-Planer zu genießen, der eine Agar-Platte mit bakteriellen Kolonien enthält. Sprichwort sagt alles: "Bakterien unterstützen - Es ist oft die einzige Kultur, die manche Menschen haben". Lassen Sie andere einen Doppelschlag mit diesem Spaß-Sprichwort-Planer mit doppelter Ausrichtung zum Thema Kultur machen!
Automatische Übersetzung
Kundenrezensionen
Es gibt bisher keine Bewertungen für dieses Produkt.Hast Du diesen Artikel gekauft?
Tags
Andere Informationen
Produkt ID: 256305183290094458
Gemacht am: 20.5.2022, 4:14
Bewertung: G
Zuletzt angesehene Produkte



